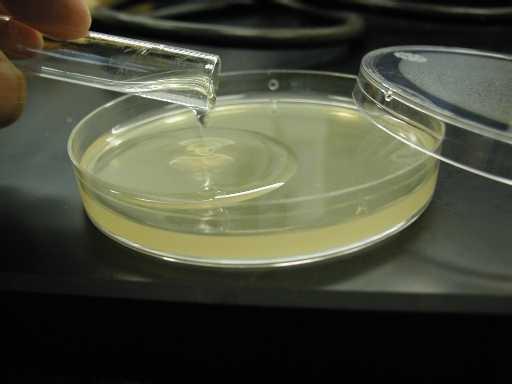
агар-агар в чашке петри

С ростом популярности молекулярной кухни мы все чаще слышим прежде незнакомые названия. Вот, например, агар-агар. Что это такое? Из чего получают это вещество? Какими свойствами обладает? Где применяется и не опасно ли его употребление? На все эти вопросы даст ответ кулинарный сайт prorosautoprom.com.
Собственно, новшеством агар-агар является только для нас. В Европе его стали применять еще в середине XIX века. А в Японии, Китае, Индии и других странах Юго-Восточной Азии история его применения идет из глубины веков. Ведь именно там со дна морей, омывающих побережья, добываются водоросли, из которых изготавливается кристальный белый порошок, обладающий великолепными желирующими свойствами. Собственно, и само слово «агар» в переводе с малайского языка означает «желе».
Из чего получают агар-агар
Свойства того или иного продукта во многом зависят от его происхождения. Из чего получают агар-агар? Это дар моря, порошок из красно-бурой водоросли филлофоры. В Юго-Восточной Азии она с давних пор употребляется в пищу и применяется в лечебных целях.
Сегодня в тропических и субтропических странах, где производят агар-агар, этот теплолюбивый вид водорослей не только вылавливают в открытом море, но и выращивают на искусственных плантациях.
Как получают агар-агар
Нежные ажурные листики багряной окраски, высыхая на солнце, обесцвечиваются. Последующее замораживание обезвоживает и без того высохшие растения. При последующей обработке органическими растворителями филлофора окончательно просушивается, превращаясь в белый порошок или пластины – агар-агар.
Высушенная водоросль, помещенная в горячую воду, полностью растворяется. При охлаждении до 40оС раствор превращается в желе. Стоит его нагреть – и субстанция опять становится жидкой, не теряя своих свойств. Эта способность делает агар-агар, не имеющий своего вкуса и запаха, великолепным загустителем.
Где производят агар-агар
Помимо вод Тихого океана, филлофора встречается и в Черном море. В Советское время завод по производству агар-агара работал в Одессе, снабжая растительным аналогом желатина кондитерские фабрики всей страны. Однако основные производители растительного загустителя традиционны:
- Япония,
- Китай,
- Марокко,
- Южная Корея.
Кроме того, сегодня для себя и поставок на мировой рынок производят агар-агар
- США,
- Португалия,
- Испания.
Основные этапы технологии остаются неизменными уже в течение нескольких веков.
Каким бывает агар-агар
В зависимости от степени очистки выделяют агар-агар первого и высшего сортов. Их легко различить по цвету порошка: первый сорт имеет желтоватый оттенок (до темно-желтого), высший – всегда белоснежен. На промышленных упаковках сорт маркируется цифрами: от 600 до 900. Чем больше число, тем выше качество продукта.
К сожалению, мелкие розничные упаковки такого обозначения не имеют. Посмотреть цвет порошка до вскрытия упаковки также невозможно. В этом случае проще всего ориентироваться на производителя: среди специалистов наилучшей признается продукция Японии.
Следует помнить, что агар-агар низкого качества может придавать блюдам неприятный привкус, характерный водорослям. Этот технологический недостаток может подчеркивать усилитель вкуса (мальтодекстрин или другая добавка).
Состав и польза агар-агара
Как и все морепродукты, в которых ценится польза, агар-агар имеет сложный химический состав. В нем содержатся:
- разнообразные полисахариды (как раз они обеспечивают желирующие свойства);
- растительные кислоты (прежде всего, ценятся глюкуроновая и пировиноградная);
- микро- и макроэлементы (цинк, кальций, железо, йод и др.);
- насыщенный витаминный комплекс.
Клетчатка, которой богат агар-агар, практически не усваивается человеческим организмом. Однако, проходя через кишечник, грубые волокна адсорбируют и выводят токсины и накопленные шлаки. Благодаря этому агар-агар считается одним из лучших средств для очищения.
Несмотря на большое количество углеводов, агар-агар низкокалориен. Жиров в его составе нет совсем. Это делает азиатский загуститель ценным диетическим продуктом для диабетиков и людей, контролирующих вес.
Все большую известность это вещество приобретает среди вегетарианцев и приверженцев здорового питания как полезный растительный аналог желатина. Кулинарный сайт prorosautoprom.com предлагает вашему вниманию таблицу – сравнение желатина и агар-агара.
| Агар-агар | Желатин |
| Растительный экстракт | Животный продукт |
| Сохраняет форму и плотную консистенцию при температуре до +40-45оС | Сохраняет желирующие свойства только при охлаждении. Уже при комнатной температуре размягчается и оплывает. |
| Очень экономичен: увеличивается в воде в 30 раз. | Для получения одинаковой густоты желе 1 ст. л. желатина соответствует 1 ч. л. агара. |
| В чистом виде не имеет вкуса и запаха. | Придает блюдам легкий мясной привкус, поэтому не идеален для кондитерских изделий и десертов. |
| В растворе совершенно прозрачен. | Слегка мутноват, что особенно заметно в желе и мармеладах. |
| Желирующие свойства обратимы: изделие можно нагреть до жидкого состояния, затем снова охладить – агар-агар не теряет своих качеств. | Продукты с желатином бесповоротно теряют плотность при нагреве. |
Выводы напрашиваются сами собой. Да, действительно, в сравнении с животным желирующим веществом растительный аналог имеет ряд преимуществ. Даже если учесть, что экзотический для России продукт дороже.
- Калорийность, стремящаяся к нулю, — неоспоримая польза агар-агара как продукта для похудения. Для тех, кто желает этим воспользоваться, рекомендуем диетические рецепты с агар-агаром.
- Благодаря исключительно растительному происхождению агар-агар подходит для веганов и постного меню.
Однако если вы не относитесь ни к одной из вышеназванных категорий и размышляете, чем заменить агар-агар в приглянувшемся рецепте, — можете использовать желатин (в некоторых случаях возможна также замена на пектин).
Где применяют агар-агар
Кулинария – основная область, где применяют агар-агар. Эта традиция азиатской кухни приобрела популярность среди европейских кулинаров (прежде всего, кондитеров) лишь в 70-е годы ХХ века. Во множестве современных кондитерских изделий среди ингредиентов эту пищевую добавку можно встретить под маркировкой Е406.
Сегодня агар-агар можно купить в свободной продаже в крупных супермаркетах (в отделах специй), в специализированных веганских магазинах и среди продуктов для диабетиков. Еще проще купить агар-агар в интернет-магазине, где можно найти продукцию любого производителя.
И в промышленных масштабах, и в домашних рецептах агар-агар добавляют в:
- мармелад и конфеты с желейными начинками;
- суфле, желе, джемы, пастилу, конфитюры;
- зефир, щербет, мороженое, кисели;
- начинки для тортов (например, «Птичье молоко»);
- диетические супы с кремообразной консистенцией;
- холодцы, заливное.
Как еще используют агар-агар
И все же приготовление пищи – далеко не единственная сфера, где находит применение агар-агар.
- Ничуть не меньшую популярность агар-агар имеет в медицине. В медицинских учреждениях он используется в виде геля, применяемого при иммунологических исследованиях, в процедурах электрофареза. В фармакологии в качестве вспомогательного вещества он вводится в состав многих лекарственных препаратов. В чистом виде в аптеки он поступает не только в виде порошка, но и в форме таблеток, капсул и рекомендуется при лечении самых различных заболеваний желудочно-кишечного тракта, эндокринной сферы, опорно-двигательного аппарата, сосудов.
- В Европу вещество в XIX веке привезли выходцы из азиатских колоний, чтобы готовить полюбившиеся экзотические блюда. Совершенно случайно оно попало к немецкому биологу Хессе, который первым дал препарату научное описание. С тех пор агар-агар использовался учеными как питательная среда при исследованиях размножения бактерий.
- Косметологи применяют агар-агар для приготовления лифтинг-масок. По мнению специалистов, подтягивающий эффект такого желе не уступает по эффекту курсу сеансов мезотерапии.
- В декоративно-прикладном искусстве мастера используют агар-агар в качестве пластификатора, добавляя в глину и другие полимерные смеси для лепки.
- Стилисты ценят агар-агар за способность защищать волосы, вместе с тем создавая эффект ламинирования.
- Отличные результаты дает применение агар-агара для похудения. Он используется для очищения кишечника, как мягкое слабительное. Желе агар-агара, принятое перед едой, притупляет чувство голода, создавая объем в желудке. С добавлением агар-агара готовятся сладкие блюда, не вредящие фигуре и допустимые во время диеты.
Имеет ли агар-агар противопоказания
Как известно, яд от лекарства отличается лишь дозировкой. Это относится и к такому замечательному продукту, как агар-агар. Противопоказания к его употреблению касаются, в первую очередь, допустимой дозы: не более 4 граммов в сутки.
- Если вы планируете использовать агар-агар для похудения или как лекарственное средство, необходима предварительная консультация врача.
- В сочетании с некоторыми продуктами (например, черным чаем и шоколадом) агар-агар способен провоцировать аллергию.
- Сочетание агар-агара с щавелевой кислотой (ее содержат щавель, шпинат, ревень) и виноградным уксусом отрицательно сказывается на желудке.
Как видите, перечень противопоказаний не велик. Полезные свойства агар-агара явно перевешивают возможные недостатки. А значит, смело можно использовать его для приготовления вкуснейших блюд для своих домочадцев и гостей.
Напоследок добавим несколько рекомендаций относительно применения этой пищевой добавки:
- При покупке агар-агара обращайте внимание на срок годности. Хранить его следует не более года – просроченный загуститель теряет свои свойства.
- Любая кислота снижает желирующие способности агар-агара. Поэтому при приготовлении блюд из кислых фруктов (мандаринов, апельсинов, яблок) лучше отдельно заварить желе, а потом уже смешивать его с кислым соком или мякотью.
- Ни в коем случае не засыпайте агар-агар в кипящую воду! При температуре выше 95оС он просто погибает. «Кипяченое» желе с агар-агаром никогда не застынет.
- Покупая агар-агар, внимательно изучайте состав, указанный на упаковке. Иногда к загустителю добавляют другие компоненты, влияющие на его свойства. При сочетании с мальтодекстрином дозировка порошка увеличивается в 2-3 раза. Увы, «поймать» необходимые пропорции поможет только опыт.
- Добавив в готовящийся мармелад побольше агар-агара, вы получите изделия с плотной, устойчивой текстурой, наподобие жевательных конфет. Они отлично подходят для украшения тортов.
Пробуйте, и у вас обязательно все получится! Кулинарный сайт «Уютная кухня» желает вам вкусных экспериментов!